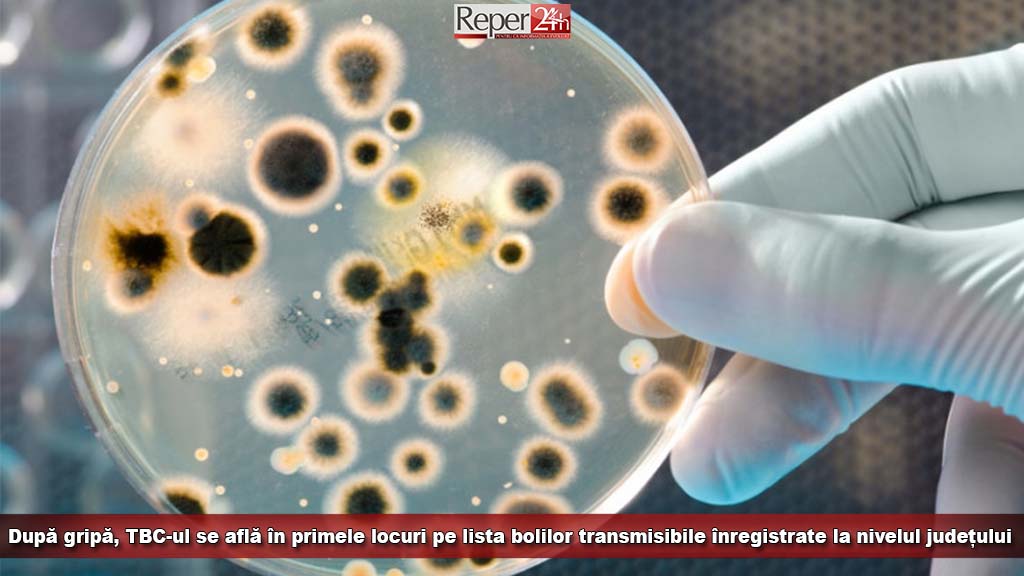
modelmic (1)

Departamentul de supraveghere în sănătate publică a făcut cunoscut numărul cazurilor de boli transmisibile înregistrate la nivelul județului Caraș-Severin în primele 4 luni ale anului 2019.
Astfel, în perioada ianuarie-aprilie 2019 la nivelul compartimentului de supraveghere epidemiologică și control boli transmisibile, s-au înregistrat 33 fișe unice de raportare a bolilor transmisibile, conform ORD. nr. 1466 din 2008, toate fiind cazuri confirmate, anunță DSP Caraș- Severin.
Dintre acestea cele mai multe sunt de hepatită virală tip A – 24 de cazuri, 1 caz de alte hepatite virale și 1 caz hepatită virala tip C.
Pe lângă acestea a mai fost confirmat un 1 caz boala Lyme, 5 cazuri de pertussis și un caz de sifilis recent.
S-au înregistrat 282 de suspiciuni de cazuri de gripa, din care s-au confirmat cu laboratorul 168 de cazuri de gripă.
Au fost raportate 7396 cazuri de infecţii acute respiratorii şi 2616 de pneumonii, 60 cazuri de boală diareică acută şi 69 cazuri de varicelă.
Tot în această perioadă de timp în județ s-au înregistrat 73 cazuri de TBC și 56 de cazuri de infecţii nosocomiale.
Numarul persoanelor infectate HIV/SIDA aflate in tratament in decursul perioadei raportate este de 202.
foto: Noi MD
Elena FRANȚ



